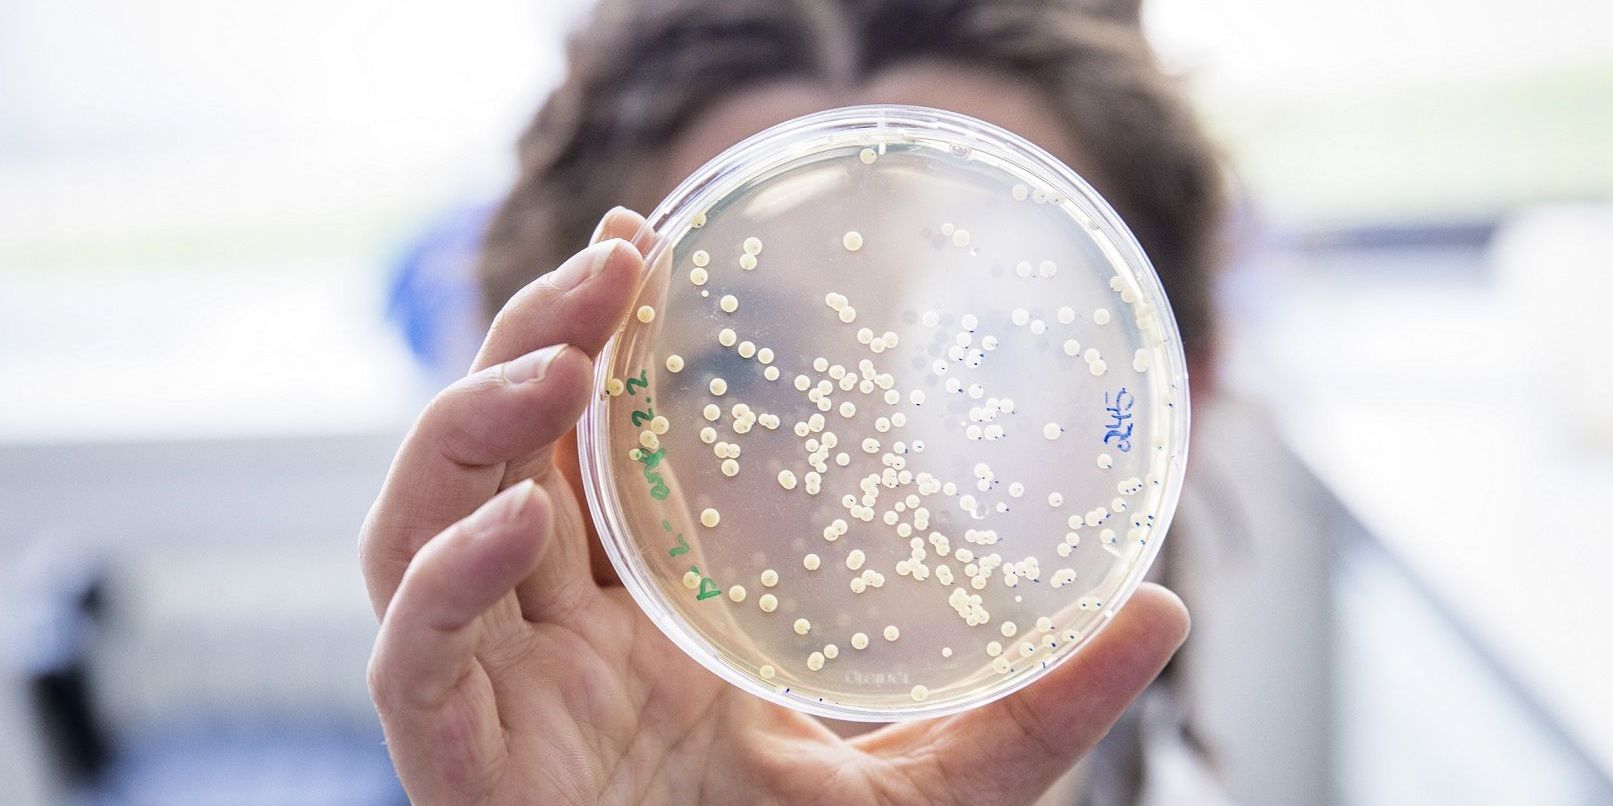
Gemeinsam stark gegen Infektionen

Gemeinsam stark gegen Infektionen
Die Konferenz „Infektionskrankheiten im 21. Jahrhundert“ wird von heute an bis zum Freitag an der Universität Jena veranstaltet. 300 internationale Experten diskutieren die neuesten Forschungsergebnisse der Infektionsforschung und Maßnahmen zur Bekämpfung von Infektionen. Höhepunkt ist der öffentliche Abendvortrag des Nobelpreisträgers Harald zur Hausen am heutigen Mittwoch. Er beginnt um 18.45 Uhr in der Aula des Universitätshauptgebäudes. Interessierte Bürger sind herzlich eingeladen; der Eintritt ist frei. cd Foto: Anna Schroll/Leibniz-HKI





















Ein paar Wolken